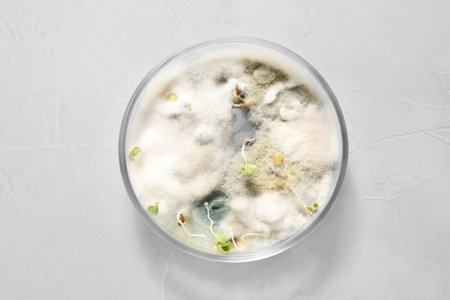
Germination and energy analysis of oat seeds in Petri dish on light table, top view. laboratory researchの写真素材

写真素材 - Germination and energy analysis of oat seeds in Petri dish on light table, top view. laboratory research
作品情報
Germination and energy analysis of oat seeds in Petri dish on light table, top view. laboratory research
- ID:210821928
- 作品種別:写真
- 作者名:liudmilachernetska
キーワード
- agricultural
- agriculture
- agronomy
- analysis
- analyzing
- background
- bio
- biochemistry
- biology
- biotech
- biotechnology
- botany
- chemistry
- dish
- energy
- examination
- experiment
- farming
- germination
- glass
- glassware
- gmo
- industry
- lab
- laboratory
- light
- mold
- natural
- oat
- object
- organic
- petri
- research
- science
- scientific
- seeds
- stone
- table
- test
- top
- view
類似作品
Female hand hol...
Petri dishes wi...
Microbiological...
Laboratory assi...
Set for growing...
Glass petri dis...
Tests for pesti...
Sprouts growing...
Germination Spr...
Seed subject to...
Seed subject to...
Celebrating ren...
Petri dish with...
Microbiological...
Germination and...
Genetically mod...
Oat flakes flyi...
Harvested oat c...
Close up of bio...
wheat grains wi...
Sprouted wheat....
Sprouts growing...
Growing wheat s...
One yellow corn...
Sapling of Shal...
GMO concept. Mi...
sprouts of corn...
Small-stemmed e...
Young seedlings...
Sprouted green ...
Science, chemis...
wheat sprouts s...
Scientist takin...
Tests for pesti...
A green vitamin...
Image of biotec...
A young lychee ...
Young seedlings...
Female hands ho...
Laboratory test...
Oats dry brunch...
Dry oat sprouts...
Spring sprouts ...
wheat sprouts s...
new harvest of ...
Small plant gro...
Transparent ste...
A rice seedling...
Cucumber vegeta...